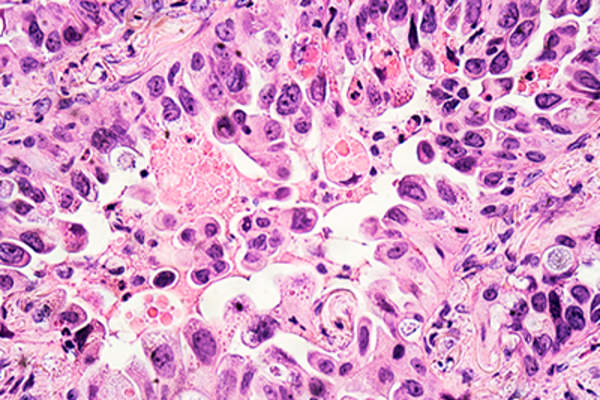
肺癌。

腺癌
腺癌是NSCLC的三种主要亚型之一,是生长在器官内壁的任何一种癌症,通常生长在产生分泌物的细胞中。腺癌是最常见的肺癌类型,在所有肺癌患者中仅占50%以上。它生长在肺泡的内层,在产生粘液的细胞中。

肺泡
肺泡是肺中氧气/二氧化碳交换的地方,肺泡是“支气管树”的末端。“大多数被诊断为非小细胞肺癌的患者都患有腺癌,这是一种生长在肺泡内壁的癌症。

肺不张
肺不能完全充气,或肺萎陷,肺不张可能是痛苦的,并产生呼吸短促。

化疗
用于杀死癌细胞的药物治疗,化学疗法是最常见的通过IV,给药虽然它也可以在药片的形式给出。虽然它有潜在的副作用的阵列,很多可以治疗使病人更舒适。非小细胞肺癌是不是响应化疗许多其他癌症,但它仍然经常结合手术管理作为初始治疗或辐射时癌症是不通过手术治疗。

CT扫描
也被称为CAT扫描或计算机断层扫描,这一系列的x射线被用来提供你肺部的详细视图,包括任何可疑的肿块。对于那些潜在的非小细胞肺癌患者,胸部CT扫描通常覆盖肝脏、肾上腺和肺,不仅用于确定肿瘤或肿瘤的位置,还用于确定附近淋巴结是否存在癌症。

大细胞癌
NSCLC的三个主要亚型的至少普遍的,大细胞癌生长在肺部的内衬;约10 NSCLC的诊断的百分比被称为大细胞。它的特点是,它生长在通常比大多数肺细胞大细胞的事实。

肺叶切除术
肺中的一个波瓣的去除;在非小细胞肺癌,肺叶切除术做是为了去除癌变组织,并试图阻止癌细胞的扩散。手术是肺癌最常用的治疗;虽然化疗和放疗是NSCLC比其他类型的癌症效果较差,这两种治疗方法往往仍然提供:化疗结合手术和放疗与化疗治疗晚期非小细胞肺癌。

纵隔镜检查
纵隔是指胸部位于肺之间的区域;纵隔镜检查是一种外科手术,可以对这个区域进行视觉观察。纵隔镜是一种带有附加光源的细管,通常是采集组织的工具,它被插入胸腔。外科医生能够在肺之间的区域寻找异常组织,并收集组织样本和淋巴结来检查癌症。

转移
当癌症从原发部位扩散到身体其他部位时,就被称为转移。发现癌症的新区域被称为转移,即met或mets。晚期NSCLC最常转移到另一个肺或大脑,但也可能转移到肝脏、肾脏、肾上腺、骨骼或肺和心脏周围的液体。

PET扫描
的PET(正电子发射断层摄影术)扫描被用于检测肺癌的任何扩散,包括晚期NSCLC,到身体的其他部位。放射性液体被注入到患者体内,和扫描仪被用于识别肺外和附近的淋巴结的任何恶性细胞。

胸膜,胸腔积液,胸膜固定术
胸膜是胸部的一对保护性膜:一个包裹着肺,一个排列在胸腔内。胸腔积液是胸膜间隙积液的术语,有时在接受NSCLC治疗的患者中会出现。这种液体的压力导致胸痛和呼吸困难。胸膜融合术是一种有助于防止胸腔积液复发的治疗方法。

全肺切除术
中,当NSCLC已传遍肺,并除去只是一个部分中使用肺手术切除一个肺的不被认为有效。

气胸
胸腔内但肺外的空气称为气胸。这种积聚的空气可以防止肺部完全膨胀,逐渐增加的压力会导致呼吸急促和胸痛。在非小细胞肺癌患者中,气胸的常见原因是手术,但也可能是由于癌症对肺或肺的广泛损害造成的。

辐射/放射疗法
使用x射线和/或伽玛射线杀死癌细胞是一种常见的治疗方法,辐射被小心地传递到尽可能多的癌症部位(和尽可能少的健康的周围组织)。虽然放疗对非小细胞肺癌的效果不如对其他癌症有效,但它经常与化疗联合使用,以帮助阻止晚期非小细胞肺癌的扩散。

段切除或楔形切除
这种切除一小部分或楔形肺组织的手术是由你的外科医生来切除你肺部的肿瘤。它是为较小的肿瘤保留的,那些还没有长到足以有效地接管肺的肿瘤。
鳞状细胞癌
其中非小细胞肺癌,鳞状细胞癌(又称表皮样癌)的三个主要亚型的约占25所有肺癌的百分比。它生长在小的,扁平的鳞状细胞衬肺的内表面上。

阶段
医生“舞台”你的肿瘤,以表明其攻击性和严肃性。您的癌症分期将有助于确定你所接受的治疗。在非小细胞肺癌,第1阶段意味着你的癌症是局限于一个肺。在第2阶段,癌细胞已经侵入附近淋巴结。阶段3吨的装置,癌症已经移动到远离在胸腔淋巴结;并且在阶段4中,癌症已行进从一个肺到其他,和/或到另一个器官,如肝脏。

胸腔
胸腔积液是指可在肺和胸壁(胸膜腔)之间的区域收集过多的液体。NSCLC患者可能会发现,无论是癌症本身或治疗引起这种积液,可引起疼痛和呼吸困难。胸腔穿刺是用于排出流体,使患者更舒适的小手术。